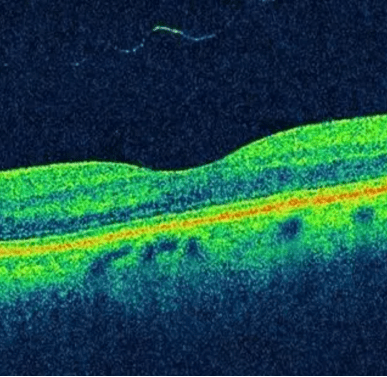
nerve fiber

If you’re a member of iConquerMS, you may have participated in a survey about MRI scans in the past. Imaging biomarkers are key tools in understanding and treating MS. Collected mainly through MRIs, these indicators offer a window into the brain and spinal cord, revealing the presence, extent, and activity of the disease. By visualizing lesions, areas of inflammation, and neurodegeneration, imaging biomarkers not only facilitate an accurate and timely diagnosis but also enable the monitoring of disease progression and the effectiveness of treatments.

Magnetic resonance imaging (MRI) is a noninvasive scan that uses strong magnetic fields, radio waves and computers to create detailed images of the brain, spinal cord or other parts of the body. It is the preferred imaging method to help diagnose MS, and to track disease activity.

Unlike an X-ray or a computed tomography (CT) scan, MRI does not rely on radiation. It is based on the fact that the body is made up of about 60% water and this water is magnetic. The MRI scanner is essentially a large, strong magnet. Water is made up of hydrogen and oxygen, and the hydrogen atoms are sensitive to magnetic fields. When a person lies inside of an MRI scanner, all of their water atoms align with its magnetic field (like a compass needle aligning to the magnetic field of the Earth). Once aligned, a radio wave is used to disturb the atoms. When the radio wave is turned off, the atoms return to the alignment. While going back they emit a signal which is transmitted to a computer, analyzed and converted into an image. Because the myelin sheath surrounding nerves is fatty, it repels water. In the areas where the myelin has been damaged by MS, the fat is stripped away. With the fat gone, the area holds more water, and shows up on an MRI scan as either a bright white spot or a darkened area depending on the type of scan that is used.
There are several different types of MRI scans. Sometimes gadolinium, a contrast agent, is given intravenously prior to the scan. Because gadolinium is a large molecule, it normally cannot pass through the blood-brain barrier. However, when there is active inflammation, the blood brain barrier is disrupted and gadolinium can enter and highlight inflamed areas.

Common MRI scans used in MS:
T-1 weighted without gadolinium – shows dark areas (hypointensities) that are thought to indicate areas of permanent brain damage.
T-1 weighted with gadolinium – shows bright areas (enhancing lesions) that indicate areas of active inflammation.
T-2 weighted – shows the total number of lesions, both old and new.
FLAIR (Fluid Attenuated Inversion Recovery) – enhances the visibility of lesions or abnormalities in the brain and spinal cord by suppressing the signal from the surrounding spinal fluid.
* The terms T-1 and T-2 refer to the time between the magnetic pulses and when the image is taken.
The McDonald criteria are a set of guidelines for diagnosing MS that include using MRI scans to detect lesions in the central nervous system. They require evidence of nerve damage in at least two out of four specific areas (three regions of the brain and the spinal cord) and proof of damage occurring at different times. Lesions must be present in multiple locations and appear or evolve over time, confirmed by new or enlarging lesions on MRI, and sometimes highlighted using gadolinium to indicate active inflammation.

MRI is an important clinical tool for diagnosing and monitoring MS. It is also invaluable to MS researchers. Are you interested in learning more? Listen to Episode 6 of our Chat with Chat webinar, entitled “Brain Scans in MS: relevance and patient experiences,” now with closed captioning!
Emerging imaging biomarkers in MS research are changing how we detect and track the disease.
Central vein sign (CVS) – MS lesions in the brain are often centered around tiny veins, a feature known as the CVS. This sign can be clearly seen with certain MRI techniques. Research has demonstrated that using the CVS for diagnosis is highly effective, with a large study underway to further confirm its value in clinical settings. Because CVS is specific to MS, it is a way to distinguish MS from other neurological diseases that may look similar, such as migraines or small vessel disease. Although it doesn’t differentiate between types of MS, the CVS is a promising tool for diagnosing the disease and could soon become a regular part of how doctors identify MS in patients.
Paramagnetic Rim Lesions (PRL) – In MS, some brain lesions stay active, even after the initial inflammation subsides and can turn into chronic active lesions (CAL). These areas can grow slowly, contributing to the worsening of MS over time. CALs can be identified on MRI because they often have a distinctive ring of iron around them. This ring is referred to as a PRL. While not every person with MS has PRLs, research shows that when they are present, especially alongside CVS, they can help confirm the diagnosis. In addition, a higher number of PRLs has been linked with more severe disability in MS, suggesting these lesions could be important for predicting how the disease might progress.
Brain Atrophy – Brain atrophy (the gradual loss of brain tissue) is another potential biomarker for MS. Research shows it occurs more rapidly in individuals MS compared to healthy adults, often leading to memory issues, depression, and fatigue. Brain atrophy is primarily due to the body’s immune system attacking the protective covering of nerves in the central nervous system, causing brain cells to be lost and the brain to shrink. The distinction between MS-related brain atrophy and normal aging remains a challenge, however, highlighting the need for further research.
Magnetic Resonance (MR) Spectroscopy – MR Spectroscopy is an advanced type of MRI scan that provides deeper insights into MS. Unlike regular MRI scans that show pictures of the brain’s structure, MR Spectroscopy yields information about the brain’s chemistry. For example, it looks at N-acetyl aspartate (NAA), a chemical made by brain cells’ mitochondria. These levels indicate whether or not brain cells and their connections are healthy. It also measures myoinositol (MI), a chemical that is related to the support cells in the brain, which helps estimate the level of brain inflammation or scarring. A study that followed 59 people with MS and 43 healthy controls over time found that by looking at the ratio of MI to NAA in areas of the brain that look normal on scans, doctors could predict the progression of MS and the rate of brain atrophy. This suggests that tracking these chemicals yields information about the damage MS causes inside the brain, often before it’s visible through other methods.
Diffusion Tensor Imaging (DTI) – DTI is another type of MRI scan that looks at how water moves inside the brain. This movement can highlight areas of nerve damage and myelin loss, as well as regions where the brain is attempting to repair itself. Researchers in Finland recently conducted a 4-year follow up study on 46 people with MS. They found that DTI may serve as a way to track disease progression, but it needs to be standardized. Investigators also state that further study is necessary to ensure DTI results are reliable over time.
Just like with any picture, resolution is an important aspect of MRI. The strength of the magnet used in the MRI machine is important in this regard. Generally, the more powerful the magnet, the better the resolution of the image produced by the MRI scan. The strength of MRI magnets is measured by a unit called Tesla (T). Most MRI scanners used in clinics have magnets of 1.5 or 3T.
Ultra-High Field MRI – Recent progress in medical imaging has led to the use of 7 or 8T magnets for brain scans, which are much stronger than those used for standard MRIs. A 2020 study suggests that these powerful MRIs may offer a way to diagnose MS earlier and with greater accuracy. Although approved, this advanced technology is not yet widely available in everyday medical settings. While these stronger scans produce clearer and more detailed brain images, they also come with challenges, including image distortion and difficulties in scanning certain brain areas. However, the advantages they offer in understanding MS are considerable. Ultra-high field MRIs can detect very small lesions on the brain’s surface and measure substances like iron or phosphorus, which standard scans can’t do. The presence of iron, in particular, can indicate inflammation and nerve damage, offering new ways to track the disease’s progression over time.
Optical Coherence Tomography (OCT) – OCT is a non-invasive imaging test that measures key areas within the retina, such as the retinal nerve fiber layer, which are important for understanding the integrity of the optic nerve. In MS, the thinning of these layers can indicate nerve damage and neurodegeneration, which are significant contributors to disability and disease progression. According to a 2018 review, OCT’s ability to detect these changes makes it a valuable tool for diagnosing MS and monitoring its course over time. Moreover, the extent of thinning observed with OCT has been linked to the severity of brain atrophy and the level of physical and cognitive disability in MS patients, underscoring its potential in assessing the overall impact of the disease on the nervous system.
The discovery and validation of new imaging biomarkers has the potential to revolutionize the diagnosis and management of MS, offering fresh insights into disease progression and the effectiveness of treatments. Advanced imaging techniques offer detailed insights into the brain and spinal cord, potentially uncovering new markers that enable earlier detection and more accurate monitoring of MS. ACP’s main goal is to support research into topics like this, which hold the promise of personalized treatment plans and improved outcomes for people with MS, marking significant progress in the battle against this challenging disease.